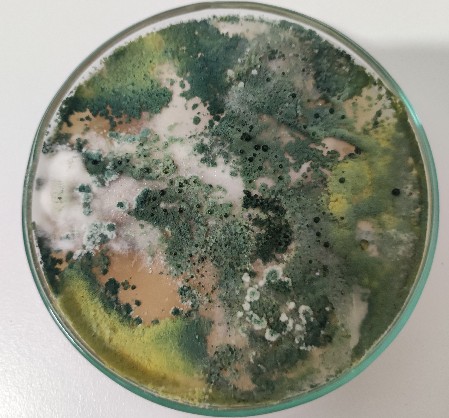

Arbuscular mycorrhiza (AM) and Trichoderma
- Directly analysis on soil to count the number of spores of mycorrhyza
- Staining of root to assess the mycorrhization index
- Directly analysis on soil and root to evaluate the presence of Trichoderma spp
- Directly analysis on soil to count the number of spores of mycorrhyza
MISSION
From prophylaxis for small farms to research for agrochemicals companies and for universities in order to improve control strategies for the protection of crops consistent with a sustainable future.

When passion supports agriculture
